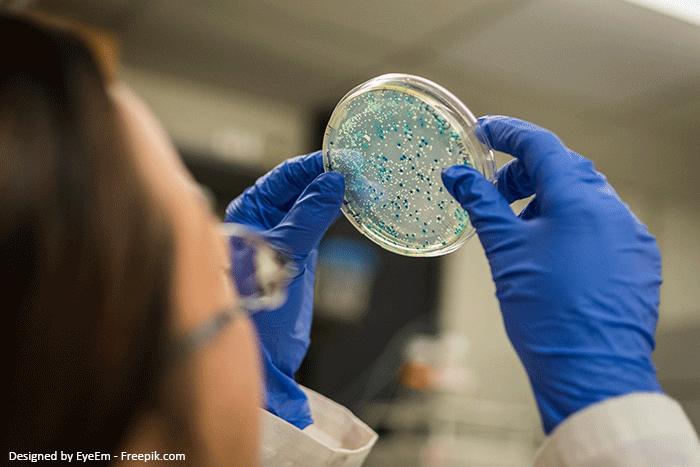
Weiterbildung Biologe

Erfahren Sie alles Wichtige zur Weiterbildung für Biologinnen und Biologen. Informieren Sie sich über Studienwege, Spezialisierungen und Zusatzqualifikationen sowie über Gehaltsaussichten und Karriereperspektiven. Zudem erhalten Sie einen Überblick über relevante Forschungsfelder, gesetzliche Vorgaben und aktuelle Entwicklungen in Biologie, Umwelt- und Lebenswissenschaften.
Inhalt
Warum ist eine Weiterbildung für Biologen interessant?
Wer bereits ein Studium im Bereich Biologie abgeschlossen hat, verfügt über ein breites naturwissenschaftliches Fundament und tiefes Verständnis für Organismen, Ökosysteme und biologische Prozesse. Um sich langfristig weiterzuentwickeln, verantwortungsvollere Aufgaben zu übernehmen und zusätzliche Karrierewege zu erschließen, kann eine gezielte Weiterbildung oder Spezialisierung entscheidend sein – sei es durch ein Masterstudium, branchenspezifische Zusatzqualifikationen oder praxisnahe Zertifikatslehrgänge.
- Mehr Verantwortung: Weiterbildungen in Bereichen wie Bioinformatik, Umwelt- und Naturschutzmanagement, Biotechnologie oder Medizinischer Biologie eröffnen den Zugang zu Projekt- und Führungsaufgaben.
- Attraktive Karrierechancen: Mit zusätzlichen Qualifikationen stehen Positionen in Forschung & Entwicklung, Labor- und Projektleitung oder im höheren öffentlichen Dienst offen.
- Gehalt & Anerkennung: Eine Spezialisierung, ein weiterführender Abschluss oder eine Promotion kann Einkommen und berufliches Ansehen deutlich steigern.
- Zukunftssicherheit: Gut ausgebildete Biologinnen und Biologen sind gefragt, da Themen wie Biodiversität, Klimawandel, Nachhaltigkeit und Gesundheit zunehmend interdisziplinär und wissenschaftlich fundiert bearbeitet werden müssen.

Biologen: Gehalt
Das Gehalt von Biologinnen und Biologen hängt stark von Faktoren wie Standort, Branche, Arbeitgeber (z. B. Hochschule, Industrie, öffentlicher Dienst) und individueller Berufserfahrung ab. Im Durchschnitt verdienen Berufseinsteiger rund 3.500 bis 4.200 Euro brutto im Monat. Mit wachsender Erfahrung, Projektverantwortung oder Führungsaufgaben können die Einkommen auf über 5.000 Euro brutto steigen – in leitenden Positionen in der Industrie oder im Management sind sogar noch höhere Gehälter möglich.
Wer zusätzliche Spezialisierungen oder Zertifikate erwirbt – etwa in den Bereichen Biotechnologie, Bioinformatik, Umwelt- und Naturschutzmanagement oder Medizinische Biologie – kann seine Verdienstmöglichkeiten deutlich verbessern. Auch ein weiterführender Masterabschluss eröffnet den Zugang zu Forschung, Entwicklung oder Managementpositionen mit entsprechend attraktiven Gehältern und Karriereperspektiven.
Berufsbezogene Weiterbildung für Biologen: Ihre Chancen im Umweltschutz
Für Biologinnen und Biologen lohnt sich eine gezielte Weiterbildung, um sich fachlich zu vertiefen, neue Kompetenzen aufzubauen und die Karrierechancen zu erweitern. Dabei stehen verschiedene Wege offen – von Spezialisierungen über Zusatzqualifikationen bis hin zu weiterführenden Studienangeboten.
Ein Masterstudium (in der Regel 3–4 Semester) ermöglicht es, das Wissen aus dem Bachelor zu vertiefen und sich in Fachrichtungen wie Umweltbiologie, Naturschutz, Biotechnologie, Bioinformatik oder Ökologie zu spezialisieren. Inhalte reichen von vertiefter Molekular- und Zellbiologie über ökologische Methoden und Umweltanalytik bis hin zu Nachhaltigkeit, Projektmanagement und Forschung. An staatlichen Hochschulen fallen meist geringe Semesterbeiträge (100–200 €) an, während private Anbieter deutlich höhere Gebühren verlangen. Förderungen sind
z. B. über Stipendien oder das Aufstiegs-BAföG möglich.
Darüber hinaus sind berufsbegleitende Weiterbildungen attraktiv, etwa in den Bereichen Ressourcen- und Umweltmanagement, Biodiversitätsforschung, Umweltanalytik oder Nachhaltigkeitsmanagement. Solche Programme bieten praxisnahe Inhalte und lassen sich parallel zum Beruf absolvieren – ein Vorteil für Biologinnen und Biologen, die ihre Karrierechancen verbessern möchten, ohne ihre Tätigkeit zu unterbrechen.

Spezialisierungen für Biologen
Biologinnen und Biologen können ihr berufliches Profil durch gezielte Spezialisierungen schärfen und sich auf bestimmte Fachgebiete vorbereiten. Besonders nach dem Bachelor- oder Masterabschluss eröffnen vertiefte Fachrichtungen attraktive Karrierewege:
- Ökologie und Naturschutzbiologie: Untersuchung von Artenvielfalt, Lebensräumen und ökologischen Wechselwirkungen. Einsatz in Naturschutzorganisationen, Umweltämtern, Planungsbüros oder Forschungsprojekten.
- Umweltanalytik: Erfassung und Bewertung von Boden-, Wasser- und Luftqualität. Tätigkeiten in Laboren, Prüfinstituten, Gutachterbüros oder Behörden.
- Mikrobiologie: Arbeit mit Bakterien, Pilzen und Viren – von medizinischer Mikrobiologie bis zur industriellen Nutzung. Beschäftigung in Laboren, Forschungseinrichtungen, Lebensmittel- und Pharmaindustrie.
- Biotechnologie: Anwendung biologischer Prozesse für industrielle, medizinische oder landwirtschaftliche Zwecke. Arbeitsfelder in der pharmazeutischen Entwicklung, Gentechnik, Agrarbiotechnologie und Umwelttechnik.

Zusatzqualifikationen – Ihr Schlüssel zum nächsten Karriereschritt
Mit einem Studium der Biologie haben Sie die Basis für Ihre Karriere gelegt. Durch gezielte Spezialisierungen und praxisnahe Zertifikate gewinnen Sie aktuelles Fachwissen, das in der Praxis gefragt ist und direkt angewendet werden kann. So erweitern Sie Ihre Kompetenzen, übernehmen mehr Verantwortung und eröffnen sich attraktive neue Karrierechancen.
Ihre Optionen als Biologe im Überblick
LAGA PN 98 Sachkunde-Schulung
Erweitern Sie Ihr Wissen in Umweltanalytik und Entsorgungstechnik: Diese anerkannte Schulung befähigt zur fachgerechten Probenahme fester Abfälle – ein starkes Plus in der Abfallanalytik, im Umweltlabor oder bei Gutachten.
➡ Mit dem Zertifikat positionieren Sie sich als Experte für Probenahme und Qualitätssicherung.
Kleiner Asbestschein
Wichtig für Biologen, die im Bereich Umweltanalytik, Sanierung oder Schadstoffgutachten arbeiten: Der „kleine Asbestschein“ qualifiziert für Tätigkeiten im Umgang mit asbesthaltigen Materialien und sorgt für Rechtssicherheit.
➡ Eine Zusatzqualifikation, die den Zugang zu Projekten im Umwelt- und Gesundheitsschutz erleichtert.
Großer Asbestschein
Das Sachkunde-Zertifikat nach TRGS 519, Anlage 3, vermittelt umfassende Kenntnisse für Abbruch-, Sanierungs- und Instandhaltungsarbeiten mit Asbest. Interessant für alle, die in Gutachterbüros, Arbeitsschutz oder Umweltbehörden tätig sind.
➡ Pflicht für leitende Personen, die Sanierungsprojekte eigenverantwortlich begleiten.
PFAS-Schulung – Unsichtbare Gefahren erkennen
Per- und polyfluorierte Alkylsubstanzen (PFAS) gehören zu den größten Umweltproblemen unserer Zeit. In dieser Schulung lernen Sie, Risiken frühzeitig zu erkennen und geeignete Maßnahmen abzuleiten.
➡ Mit diesem Wissen sind Sie auf einem hochaktuellen Zukunftsfeld spezialisiert.
Ersatzbaustoffverordnung (EBV) – Grundlagenkurs
Vermittelt Spezialwissen zu Kreislaufwirtschaft, mineralischen Ersatzbaustoffen und Gütesicherung. Ideal für alle, die im Bereich Umweltanalytik, Ressourcenmanagement oder Nachhaltigkeitsgutachten arbeiten.
➡ Damit erweitern Sie Ihr Profil im nachhaltigen Bauen und Umweltschutz.
VDI-Schulungen (z. B. 2047, 6022, 6023)
- VDI 2047 – Kühlturme: vermittelt Know-how für den sicheren Betrieb von Rückkühlwerken und Verdunstungskühlanlagen, inklusive Legionellenprävention.
- VDI 6022/6023 – Hygieneschulungen: Hygieneschulungen mit Fokus auf Trinkwasser- und Raumluft-Hygiene.
➡ Ideal für Biologen mit Schwerpunkt Mikrobiologie, Umweltanalytik oder Hygiene.
Abwasser-Probenahme-Schulung – Fachkunde
In dieser Weiterbildung erwerben Sie fundierte Kenntnisse zur fachgerechten Abwasserprobenahme nach dem AQS-Merkblatt P 8/1 der LAWA. Behandelt werden dabei gesetzliche Vorgaben, Qualitätssicherung und Hygienestandards. Damit erweitern Sie Ihr Fachwissen um eine praxisnahe Zusatzqualifikation, die sowohl in der Wasserwirtschaft als auch in der Umweltanalytik von zentraler Bedeutung ist.
➡ Mit dem Zertifikat weisen Sie Ihre Kompetenz im Gewässer- und Umweltschutz nach und stärken Ihr berufliches Profil.
AwSV-Grundlagenkurs (Anlagen zum Umgang mit wassergefährdenden Stoffen)
Dieser Kurs vermittelt Ihnen die aktuellen Vorgaben der AwSV (Verordnung über Anlagen zum Umgang mit wassergefährdenden Stoffen) in Verbindung mit dem Wasserhaushaltsgesetz. Sie erfahren, wie sich Gewässerschäden vorbeugen und hohe Sanierungskosten vermeiden lassen. Um rechtlich stets auf dem neuesten Stand zu bleiben, ist in der Regel alle zwei Jahre eine Auffrischung vorgesehen.
➡ Mit diesem Zertifikat weisen Sie Ihre Fachkompetenz im sicheren Umgang mit wassergefährdenden Stoffen nach und stärken Ihr berufliches Profil.
Grundlagen des Wasserrechts
Diese Schulung vermittelt Ihnen vertiefte Kenntnisse zu den rechtlichen Grundlagen des Gewässerschutzes. Im Mittelpunkt stehen Themen wie Genehmigungsverfahren und der Besorgnisgrundsatz zur Vermeidung von Umweltgefahren. Besonders nützlich ist dieses Wissen für Biologinnen und Biologen, die in Forschung, Umweltgutachten, Behörden oder im Umweltmanagement tätig sind.
➡ Mit dieser Zusatzqualifikation erweitern Sie Ihr Profil im Umweltrecht und qualifizieren sich für verantwortungsvolle Aufgaben im Gewässer- und Naturschutz.

Gesetze, Richtlinien und Verordnungen für Biologen
Für Biologinnen und Biologen bilden Gesetze, Richtlinien und Verordnungen eine zentrale Grundlage ihres beruflichen Handelns. Besonders wichtig sind dabei das Bundesnaturschutzgesetz, das den Schutz von Arten und Lebensräumen regelt, das Bundes-Immissionsschutzgesetz für Luft- und Lärmschutz, das Kreislaufwirtschaftsgesetz zur Förderung von Abfallvermeidung und Recycling sowie das Wasserhaushaltsgesetz, das Oberflächen- und Grundwasser schützt. Auch die Trinkwasserverordnung spielt eine entscheidende Rolle, da sie die hohe Qualität der Trinkwasserversorgung sicherstellt.
Ergänzt werden diese rechtlichen Grundlagen durch technische Vorschriften wie die Technischen Regeln für Gefahrstoffe, die beispielsweise beim Umgang mit Schadstoffen Anwendung finden, sowie durch Umweltmanagement-Standards wie ISO 14001 oder EMAS.
Biologinnen und Biologen, die in Umweltanalytik, Forschung, Naturschutz oder Behörden tätig sind, müssen diese Rahmenbedingungen beherrschen, um Projekte fachgerecht und rechtssicher umzusetzen und gleichzeitig einen wirksamen Beitrag zum Schutz von Mensch, Tier und Umwelt zu leisten.

Biologen: Ausbildung
Der Einstieg in den Beruf erfolgt in der Regel über ein Hochschulstudium im Fach Biologie oder in verwandten Lebenswissenschaften wie Biochemie, Biotechnologie oder Umweltwissenschaften. Voraussetzung ist meist die allgemeine Hochschulreife, in einigen Fällen auch die Fachhochschulreife. Unter bestimmten Bedingungen kann auch eine berufliche Qualifikation mit entsprechender Praxiserfahrung den Zugang ermöglichen.
Voraussetzungen: Angehende Biologen sollten ein starkes naturwissenschaftliches Interesse, analytisches Denken und eine sorgfältige Arbeitsweise mitbringen. Kommunikationsfähigkeit und Teamgeist sind wichtig, da häufig in interdisziplinären Projekten gearbeitet wird.
Studieninhalte: Das Studium umfasst Fächer wie Zoologie, Botanik, Genetik, Mikrobiologie, Zell- und Molekularbiologie sowie Ökologie und Evolution. Ergänzend werden Methoden der Biostatistik, Bioinformatik und Umweltanalytik vermittelt. Ein Masterstudium eröffnet die Möglichkeit zur Spezialisierung und zu verantwortungsvolleren Aufgaben.
Perspektiven: Absolventinnen und Absolventen arbeiten in Forschungseinrichtungen, Universitäten, Laboren, Biotech- und Pharmaunternehmen, Umweltorganisationen und Behörden. Mit zunehmender Erfahrung stehen auch Projektleitung, Managementaufgaben oder wissenschaftliche Leitungsfunktionen offen.
Schulungen, die für Biologen interessant sind:
-
Online-Schulung | Mehr Details >
- 08.09.2026 (Online)
- 16.11.2026 (Online)
-
Präsenz-Schulung
-
Online-Schulung | Mehr Details >
- 16.06.2026 (Düsseldorf)
-
Präsenz-Schulung
-
Online-Schulung | Mehr Details >
- 08.07.2026 (München)
- 23.09.2026 (Leipzig)
- 02.12.2026 (Düsseldorf)
-
Online-Schulung | Mehr Details >
- 22.05.2026 (Online)
- 01.07.2026 (Online)
- 04.09.2026 (Online)
-
Präsenz-Schulung
-
Online-Schulung | Mehr Details >
- 11.06.2026 (Online)
- 23.06.2026 (Hannover)
- 24.06.2026 (Münster)
-
Präsenz-Schulung
-
Online-Schulung | Mehr Details >
- 16.06.2026 (Online)
- 16.09.2026 (Online)
- 19.11.2026 (Online)
-
Online-Schulung | Mehr Details >
- 02.06.2026 (Online)
-
Präsenz-Schulung | Mehr Details >
- 31.08.2026 (Hamburg)
- 02.12.2026
-
Präsenz-Schulung
-
Online-Schulung | Mehr Details >
- 19.05.2026 (Online)
- 10.06.2026 (Stuttgart)
- 02.07.2026 (Online)
-
Präsenz-Schulung
-
Online-Schulung | Mehr Details >
- 02.07.2026 (München)
- 13.07.2026 (Stuttgart)
- 21.09.2026 (Leipzig)
-
Präsenz-Schulung
-
Online-Schulung | Mehr Details >
- 02.07.2026 (München)
- 21.09.2026 (Leipzig)
- 07.12.2026 (Düsseldorf)
-
Präsenz-Schulung
-
Online-Schulung | Mehr Details >
- 08.09.2026 (Online)
- 25.11.2026 (Online)
-
Präsenz-Schulung
-
Online-Schulung | Mehr Details >
- 02.06.2026 (Online)
- 09.06.2026 (Online)
- 01.09.2026 (Online)
-
Präsenz-Schulung | Mehr Details >
- 18.06.2026 (Düsseldorf)
- 21.10.2026 (Stuttgart)
- 22.10.2026 (München)
-
Online-Schulung | Mehr Details >
- 03.06.2026 (Online)
- 07.07.2026 (Online)
- 11.09.2026 (Online)
Häufige Fragen und Antworten
Biolog/innen erforschen Lebewesen und ihre Lebensprozesse in natürlichen oder künstlichen Umgebungen. Sie untersuchen Pflanzen, Tiere, Mikroorganismen oder Zellen, analysieren Wechselwirkungen innerhalb von Ökosystemen und erforschen biologische Abläufe, um Erkenntnisse für Wissenschaft, Umwelt, Gesundheit oder Technik zu gewinnen.
Biolog/innen sind in verschiedenen Bereichen tätig, darunter Forschungseinrichtungen, Hochschulen, Umwelt- und Naturschutzbehörden, Biotechnologie- und Pharmaunternehmen, sowie Labor- und Analytikdienstleister. Sie arbeiten an Fragestellungen zu Artenvielfalt, Lebensraum-Schutz, medizinischen Anwendungen, ökologischer Bewertung oder technologischen Entwicklungen.
Für den Beruf ist in der Regel ein Studium der Biologie oder eines verwandten naturwissenschaftlichen Fachs erforderlich. Wichtige Kompetenzen sind analytisches Denken, praktische Labor- und Feldarbeitserfahrung, Kenntnisse in Datenanalyse und wissenschaftlicher Methodik sowie die Fähigkeit, Forschungsergebnisse klar zu dokumentieren und zu präsentieren. Zusammenarbeit in interdisziplinären Teams ist häufig Teil der Arbeit.
